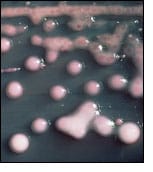

Prophecy News: September 2010
Oceanic Dead Zones
Add oceanic dead zones to the world’s environmental concerns. This is not just an area with a small die off or a spill of a pollutant. We are talking about areas of tens of thousands of square kilometers where virtually all marine life has been killed. Such areas are occurring with increasing frequency. And marine plants are responsible for a large part of the production of our oxygen supply.
In this month’s newsletter, I am sharing this story about oceanic dead zones with some of my own thoughts about it and a variety of other items.
Note that I am simply sharing items of interest. That does not imply that I agree with everything presented.
Prophecy News: 2010 SEPTEMBER
Oceanic Dead Zones – General Collection
serc.carleton.edu

“Lists of resources such as news articles, web sites, and reference pages provide a comprehensive array of information about oceanic dead zones — shown in the Gulf of Mexico and worldwide!
Scientists work to explain why massive “oceanic dead zones” have been invading the Pacific Northwest’s near-shore waters since 2002
Yet another ecological scourge may earn a place on the ever-lengthening list of problems potentially caused by climate change: the formation of some so-called “oceanic dead zones” – huge expanses of ocean that lose virtually all of their marine life at depth during the summer.
Possible connections between climate change and the relatively recent formation of dead zones in the Pacific Northwest’s coastal waters are currently being studied by a research team that is funded by the National Science Foundation and co-led by Jack Barth of Oregon State University (OSU) and Francis Chan of OSU. (Jane Lubchenco, who is currently on leave from OSU while serving as the Administrator of the National Oceanic and Atmospheric Administration, also previously co-led the team.)
WORLDWIDE OCEANIC DEAD ZONES
The Earth currently has more than 400 oceanic dead zones, with the count doubling every decade. A single dead zone may cover tens of thousands of square miles.
Dead zones form where microscopic plants, known as phytoplankton, are fertilized by excess nutrients, such as fertilizers and sewage, that are generated by human activities and dumped into the ocean by rivers, or more rarely, where they are fertilized by naturally occurring nutrients. The result: blooms of organic matter that ultimately decompose through processes that rob the ocean of life-sustaining oxygen. Animals that fail to flee oceanic dead zones either suffocate or suffer severe stress.
Ray’s comments
This topic of oceanic dead zones is of interest to me, as I used to work as a marine fisheries biologist for the Dept. of Fisheries and Oceans and even take water samples at depth off the coast.
It is also of interest right now because I am doing a detailed study on the effect of the plagues of Revelation 16 on the state of the earth. One of the plagues could result in dead zones in the ocean or perhaps all the oceans:
“And the second angel poured out his vial upon the sea; and it became as the blood of a dead man: and every living soul died in the sea.” (Rev 16:3)
We can see from reports like the one above how the sea can become like the blood of a dead man. Like it in that it is anoxic (without oxygen and therefore not capable of supporting life), not red – it is not very red anyway; only freshly-oxygenated blood is bright red.
Another verse seems to indicate that the waters will be even more like blood than just being low in oxygen:
“For they have shed the blood of saints and prophets, and thou hast given them blood to drink; for they are worthy.” (Rev 16:6)
I won’t be very pleasant water in any case. We can be thankful for the promise to the righteous:
“He that walketh righteously … bread shall be given him; his waters shall be sure.” (Isa 33:15-16)
Watch for my study on the effects of the plagues; how they will reduce the earth to a completely uninhabitable state. This shows the impossibility that the saved will spend the millennium on earth fixing it up as some believe. It will not be capable of supporting life. My study on the millennium is posted now and will include a link to my study on how the plagues reverse creation when it is done. That should be later this month as I am doing presentations on these topics at some meetings in Oyama, BC later this month.
Super Alert: New Superbug Spreading Around the World
earthweek.com / August 20, 2010
“A dangerous new enzyme that can allow any bacteria to become a superbug, resistant to all known antibiotics, is causing alarm among health experts worldwide.
“Known as NDM-1, the enzyme appears to have emerged in South Asia last year and has since been spread back to the home countries of patients who visited Pakistan and India for discounted medical procedures like cosmetic surgery.
“So far, the number of people identified as carrying the enzyme is small, including 37 in the U.K. and three from Australia. Cases in Canada and the U.S. have also been reported.
“The death of a Belgian man linked to the superbug is believed to be the first fatality from it in the world.
“‘We are potentially at the beginning of another wave of antibiotic resistance, though we still have the power to stop it,’ said Christopher Thomas, a professor of molecular genetics at the University of Birmingham.
“Earlier this month, a chemical compound called GSK 299423 was found effective against antibiotic-resistant bacteria. Some believe this could become a treatment for the new NDM-1 strain.”
Australian Swarms
EARTHWEEK.com / August 20, 2010

“The worst locust swarms in nearly 30 years are expected to ravage crops across parts of Australia in the coming months.
“Unusually wet weather earlier this year allowed hundreds of millions of spur-throated locusts to breed, especially in western Queensland.
“Officials have launched an intense spraying assault on existing swarms before they get a chance to reach prime agricultural areas.
“‘The (southern) winter months are the ideal time for spraying, as locusts band together in swarms and present a good target,’ Primary Industries Minister Tim Mulherin told the Australian Associated Press.
“Recent warm weather may mean the insects could begin moving earlier than expected.”
Above we read of oceanic dead zones. Some people are predicting almost the economic equivalent an economic dead zone, an economy that might not sustain much of anything.
U.S. Is Bankrupt and We Don’t Even Know It: Laurence Kotlikoff
By: Laurence Kotlikoff / Bloomberg.com / August 10, 2010

“Let’s get real. The U.S. is bankrupt. Neither spending more nor taxing less will help the country pay its bills.
“What it can and must do is radically simplify its tax, health-care, retirement and financial systems, each of which is a complete mess. But this is the good news. It means they can each be redesigned to achieve their legitimate purposes at much lower cost and, in the process, revitalize the economy.”
Doomsday Warnings of US Apocalypse Gain Ground
Breibart.com / August 20, 2010

“Economists peddling dire warnings that the world’s number one economy is on the brink of collapse, amid high rates of unemployment and a spiraling public deficit, are flourishing here.
“The guru of this doomsday line of thinking may be economist Nouriel Roubini, thrust into the forefront after predicting the chaos wrought by the subprime mortgage crisis and the collapse of the housing bubble.
“‘The US has run out of bullets,’ Roubini told an economic forum in Italy earlier this month.
“Boston University professor Laurence Kotlikoff, who warned as far back as the 1980s of the dangers of a public deficit, lent credence to such dark predictions in an International Monetary Fund publication last week.
“He unveiled a doomsday scenario — which many dismiss as pure fantasy — of an economic clash between superpowers the United States and China, which holds more than 843 billion dollars of US Treasury bonds.
“‘A minor trade dispute between the United States and China could make some people think that other people are going to sell US treasury bonds,’ he wrote in the IMF’s Finance & Development review.
“And the view that America is on a decline seems rather well ingrained in many people’s minds supported by 65 percent of people questioned in a Wall Street Journal/NBC poll published last week.
“New York Times editorial writer David Brooks . . . said the United Sates is losing its world dominance much in the same way the British Empire began to crumble more than a century ago.”
Ray’s note: And, of course, there are more stories of the threat of war. You’ll remember, if you have read my study on Daniel’s vision of Daniel chapter 8, that there seems to be a brief time of prosperity indicated following this coming war.
Just One Trigger Finger Can Do It
By: Jerry Golden / The Golden Report.com / August 14, 2010

“With Hezbollah, Hamas, Lebanon, Syria, and Iran all on the highest alert, and all five literally sitting a few hundred yards apart — staring at each other with loaded guns — it will only take one trigger-happy soldier to plunge this whole planet into the Third World War.
Not to mention the political unrest in Iran which is about to upset the plans of Ahmadinejad.
He believes that he has been called by his ‘god’ to reveal the 12th Imam who will establish Islamic global control after a catastrophic war from which Persia apparently emerges victorious. Ahmadinejad desperately wants this war to begin — and soon.”
“Iran On Verge of Potential US-led War”
A top Iranian commander has warned of a potential US-led war against Iran in the near future, insisting on enduring readiness of Iran’s defense forces to repel any attack.
PressTV.com / September 19, 2010

“Major General Gholamali Rashid said that under ‘current threatening conditions’ when the US and Israel are ‘daily beating on their war drums,’ it would not be an exaggeration to say that we are on the verge of a potential war in the [near] future.
“Gen. Rashid’s remarks came following his description of threats made by the US and Israel against countries of the region after the ‘suspicious September 11 incident.’
“Rashid also added that he does not think that US military commanders would commit such a strategic mistake of an all-out war, ‘since they are militarily incapable of waging a ground war against Iran.’
“He also expressed doubt about a US aerial or missile attack against Iran, adding that they are well-aware of Iran’s great deterrence capacity, missile power, and enhanced sea defense potentials.”
So that’s it for this month – oceanic dead zones, other health and environmental problems, economic woes and a coming war. Remember, beyond all the bad news, there is good news. Very good news indeed of Jesus’ soon second coming and the end of all these problems.
